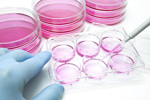
cellular-assay-GettyImages-1181981719

ARTICLES BY BIOPHORUM
-
Rethinking CQV In A Digital, Agile Manufacturing Landscape5/21/2026
While commissioning, qualification, and validation (CQV) remains foundational, the way it is planned and executed must evolve to keep pace with modern manufacturing realities.
-
Closing The MES Value Gap: Why Technology Isn't The Problem5/14/2026
Manufacturing execution system (MES) technical maturity is rising, but adoption across manufacturing sites is uneven. Organizational readiness may hold the key.
-
Why Your MES RFP Is Failing Before It Starts5/6/2026
Many manufacturing execution system requests for proposals fail. Not because vendors cannot deliver or the tech is immature, but because the requirements are written backward.
-
Quantifying Single-Use Waste Produced During mAb Manufacture4/2/2026
Discover the current scale of plastic single-use technology waste and its projected growth, specifically for the biomanufacturing domain. There is an increasing need for sustainable solutions.
-
SUS Interchangeability Assessment And Qualification Best Practices3/12/2026
Establishing a robust single-use systems (SUS) interchangeability program can be a pivotal feature of a supply chain resiliency initiative.
-
MES Is Still In The CD ROM Era But The Data Architecture Has Moved On2/20/2026
Many manufacturing execution system (MES) deployments still operate like it is 2005: a big install, disruptive upgrades, etc. Here's a clearer path forward.
-
Contamination Control Strategies In Low Bioburden Biologic Drug Substance Manufacturing12/15/2025
How do manufacturers apply a contamination control strategy in a non-sterile world, particularly at a low bioburden biologic drug substance manufacturing site? How can Annex 1 apply?
-
How To Improve Sponsor–CMO Collaboration Around Digital Deviations11/17/2025
Digital strategies and standardized data models cut manual work, boost accuracy and speed of information sharing, and build trust between sponsors and CMOs.
-
Guidelines For Defining A Control Strategy Framework For Accelerated mAb Programs11/6/2025
This article assembles an industrywide “platform” knowledge base on the impact of parameters across unit operations in a standard mAb process.
-
Import Product Specifications And Drug Registration Testing For China10/6/2025
This overview and its recommendations are valid for drug registration testing (for marketing authorization application in China) as well as import testing (for commercial batches to be imported to China after approval).
-
Environmental Monitoring Performance Qualification In New Drug Manufacturing Facilities8/1/2025
In setting up a new manufacturing facility, a robust process for environmental monitoring must be established and cleanrooms in the classified areas must be properly qualified. Here are critical considerations to keep in mind.
-
A Road Map For PAT Monitoring And Control5/8/2025
Process analytic technology monitoring and control is rapidly progressing. BioPhorum shares new best practices on how to move from concept through life cycle management and/or regulatory approval of the PAT application.
-
A Practical Guide To Defining Priority Data In MES3/17/2025
Manufacturing execution systems (MES) play a crucial role in pharma/biotech, but MES platforms face the challenge of identifying the critical data that should be prioritized for supporting effective operations.
-
Digital Certificates Of Analysis: A Vision For The Transfer Of Quality Data1/23/2025
The pharma/biotech industry must ramp up adoption of digital certificates of analysis, which are transforming the way quality data is transferred between organizations in the supply chain.
-
A Justification For Using In-Process Controls In Place Of Cleaning Validation1/9/2025
This article provides a procedure for using and cleaning shared columns and column packing equipment and using in-process controls that eliminate the need for cleaning validation.
-
A Risk-Based Approach To Filter Integrity Testing Annex 1 Requirements For Biologics DS11/8/2024
How do the principles of filter integrity testing described in EudraLex Annex 1 apply to low bioburden drug substance manufacturing? And how can using a risk-based approach help?
-
A Phase-Appropriate Approach For Assay Validation In Cell & Gene Therapies10/2/2024
This article promotes alignment on a common phase-appropriate approach to analytical assay validation with respect to the critical quality attributes of the most common cell/gene therapy modalities.
-
How To Leverage Platform And Process Characterization Data To Accelerate Cell & Gene Therapies9/10/2024
This article discusses how cell and gene therapy companies can use prior knowledge and platforms to leverage process characterization to reduce the testing and/or studies required during process validation for drug substance and drug product manufacturing processes.
-
How To Minimize The Impact Of Stability Testing On Gene Therapy Batch Yield8/27/2024
This article outlines strategies for reducing the volumes required for gene therapy stability studies, with the goal of conserving product for patients, while remaining compliant and delivering data on CQAs.
-
End-To-End mRNA DS And DP Manufacturing Processes7/10/2024
This article demystifies the manufacture of mRNA encapsulated in lipid nanoparticles across unit operations for plasmid linearization, drug substance (DS) manufacture, and drug product (DP) manufacture.
-
A Holistic Approach To Container Closure Integrity5/20/2024
Regulations are pushing for an approach to container closure integrity that builds quality into the design and processes rather than testing/inspecting the manufactured item.
-
How To Unlock Efficiency In MES Integrations5/16/2024
This article outlines the significant benefits and framework for manufacturing execution system (MES) integration with systems such as enterprise resource planning.
-
Evaluating, Validating, And Implementing NAT-Based Mycoplasma Detection Methods5/3/2024
Regulatory authorities advocate using alternative adventitious agent tests, but adoption has been slow. Here’s how to validate an alternative mycoplasma detection assay.
-
Developing A Process Performance Qualification Master Plan For Gene Therapies4/19/2024
This article provides considerations and a framework for a Process Performance Qualification Master Plan in the gene therapy industry. It is useful for sponsors with any level of experience.
-
Developing & Implementing A Continuous Bioprocess Control Strategy2/20/2024
A key challenge to better uptake of continuous processes in biologics manufacturing is the necessity to link unit operations. This article defines a standard template approach for developing and implementing a continuous bioprocessing control strategy, providing a visual and technical aid, and sharing considerations when selecting control schemes.
-
Strategies For Minimizing The Impact Of Bioburden And Sterility Testing On Gene Therapy Batch Yield1/2/2024
It is widely recognized that gene therapy manufacturing processes result in low yields. This article outlines strategies for reducing the volumes required for bioburden and sterility testing and, therefore, conserving product for patients while remaining compliant and delivering process information on the microbiological status.
-
Understanding CQAs For mRNA/Lipid Nanoparticle Product Development And Manufacture12/13/2023
BioPhorum recently created a resource of potential critical quality attributes (CQAs) for mRNA products from the early stages of drug development to commercial manufacturing. We asked two of the paper’s authors some questions to explore the key areas in more detail.
-
Proposed Best Practices For Cell & Gene Therapy Aseptic Process Simulation10/25/2023
Aseptic process simulation (APS) plays a critical role in demonstrating that the processes, equipment, and materials involved in sterile manufacturing work in synergy to maintain sterility. Applying existing APS guidelines to cell and gene therapies/ATMPs can be challenging, so BioPhorum proposes a best practice approach in alignment with regulatory guidance.
-
Considerations For Viral Clearance In Cell And Gene Therapy7/27/2023
Assuring viral safety in cell and gene therapy (CGT) products poses a unique challenge. This article focuses on adeno-associated viral (AAV) vectors but also applies to other viral vectors where possible.
-
A Practical Proposal For Standardizing Traceability Of Cell And Gene Therapies7/21/2023
For personalized therapies, it is imperative that patients are treated with the product meant specifically for them. Mistakes in products or on labels that lead to the wrong therapy being administered to the patient are likely to have fatal consequences. BioPhorum presents a practical vision for standardizing the traceability of cell and gene therapies across the value chain.
-
Container Closure Integrity Testing Strategies For Gene Therapies6/7/2023
Container closure integrity testing (CCIT) has been recognized as having a significant impact on batch yield. This article provides perspectives on CCIT strategies to minimize the impact on gene therapy drug product batch yield by examining recent industry survey results as well as best practices.
-
Improving Digital Integration Between Biomanufacturers & Partners5/1/2023
Sponsors are working with more contract organizations, and contract organizations are working with more sponsors. There is often a mismatch in digital maturity (IT capabilities) between the two sides of a partnership. We must work toward a bidirectional sharing of data and process knowledge. This road map from BioPhorum will help.
-
Risk-Based Strategies For Revalidating Bio/Pharma Equipment & Systems4/20/2023
While equipment and systems validation is a regulatory requirement, it would take thousands of annual tests to retest all equipment and systems. BioPhorum shares risk-based approaches to new product introduction, controlled temperature chambers, sterilization processes, and more.
-
Best Practices For Cell Culture Media Fingerprinting3/13/2023
This three-tier approach to cell culture media fingerprinting helps you to define an alternative method that will allow verification of the quality of the medium as well as fingerprinting. It helps you to choose suitable methods for incoming ID testing based on raw material properties, goals of media characterization, and the resources available.
-
Using QbD Principles To Register Innovative Raw Materials2/13/2023
Control of biopharmaceutical raw materials is defined by the license holder. We propose a best practice approach to registering innovative and complex raw materials based on quality by design (QbD) principles. It can be applied to different families of non-compendial raw materials used when manufacturing biologics.
-
Release Specifications For Plasmid MCBs, Plasmid DNA1/10/2023
Plasmid release specifications are critical to the manufacture of many cell and gene therapy products, but current guidance defining expectations for the release of plasmids as a starting material is limited. In this article, BioPhorum summarizes key industry feedback, best practices, and member discussions on the topic.
-
A Methodology To Support Particle Investigations In Biopharma Products11/22/2022
Particles in parenteral products are a major cause of product recalls, and appropriate management of risk from visible particles is vital. This standardized methodology provides users with a decision-making tool to clarify the risks presented by a particle to a batch.
-
A Phased Approach To Adopt In-Line Monitoring & Real-Time Release10/26/2022
The biotech plant of the future will use in-line monitoring (ILM) and real-time release (RTR), which includes process technology, operational systems, facility design, and construction innovations that will increase capacity and enable efficient processes. This article is a guide to adopting that vision.
-
Biopharma Facility Modular Design & Construction: Key Considerations9/12/2022
In facility design, the term “modular design block” is used for “pre-engineered” or “predesigned” solutions. This approach suggests that a new facility design need not be unique but can use and leverage a pre-engineered set of component pieces. The further down the supply chain standardized modules and components reach, the wider the benefits.
-
Qualifying Working Cell Bank Replenishment9/6/2022
Cell banks represent the fundamental starting substrates for biological drug substance/drug substance intermediate manufacturing. The availability of well-characterized cell banks is imperative to ensure drug product supply. This article shares regulatory tips for cell bank registration and regulatory considerations when replenishing a working cell bank.
-
The Process Map To Ensure Biopharma Raw Materials Supply8/16/2022
In new product introduction, there is often a lack of a basic data package for a product being scaled up for clinical or launch supplies. This can lead to several issues, e.g., capacity and lead time restrictions, oversupply, and more. A stepwise process can be used as a guideline for introducing a material to support new drug substance manufacture.
-
How To Test Master Cell Banks As A Starting Material For Gene Therapies6/10/2022
BioPhorum’s Cell and Gene Therapy Raw Materials team suggests a platform approach for testing a critical starting material for gene therapies – master cell banks (MCBs). This can ultimately influence and/or aid regulatory agencies when developing guidance or policies around gene therapy development and manufacturing.
-
Overcome Potency Assay Development Challenges In Gene Therapies4/22/2022
In gene therapy development and manufacturing, developing and validating appropriate potency assays that reflect the mechanism of action acceptable to regulators is a process fraught with challenges. The FDA advocates the use of a matrix approach, and this article shares best practices of this approach.
-
Proposed Solutions For Cell & Gene Therapy Validation Challenges1/21/2022
As more experience and knowledge are gained on cell and gene therapy manufacturing processes, some challenges will be resolved and others will be identified. This article delves into challenges and proposed solutions for manufacturing process validation, designing PPQs for autologous cell therapy, and analytical method validation.
-
How To Integrate CPV & APR For Biologics1/3/2022
In biologics manufacturing, continued process verification (CPV) requirements are similar to those for evaluating quality standards that determine changes to manufacturing or control procedures in an annual product review (APR). Many companies have mirrored CPV and APR reporting processes. Few have realized the efficiencies of integrating them.
-
Solving The 4 Serialization Challenges Of Track & Trace11/17/2021
More than 10 years after introducing track and trace, the pharmaceutical industry still faces a number of technical challenges and limitations related to regulatory expectations, with many companies still transforming their packaging operations to meet them.
-
How To Mitigate The Risks Posed By "High-Risk" Host Cell Proteins11/3/2021
Host cell proteins are process‐related impurities that may copurify with biopharma drug products. Some of these can be considered high-risk, including those that are immunogenic, biologically active, or enzymatically active with the potential to degrade molecules or excipients used in formulation. Here's how to mitigate those risks.
-
Computerized Systems Validation And Audit Trail Requirements10/18/2021
A plug-and-play approach can significantly impact how we design, build, and operate biopharma facilities. Yet, innovative developments create industry adoption challenges. This article summarizes two recently released BioPhorum standards: Plug-And-Play Computerized Systems Validation Strategy and Plug-And-Play Audit Trail Requirements.
-
Best Practices For Raw Material Supplier Change Notifications: New BioPhorum Guidance8/27/2021
Managing the large volume of supplier change notifications while safeguarding the continuity and compliance of a complex and tightly regulated supply chain is a resource-intensive task. To address the challenges, the BioPhorum Raw Material Variability Workstream has developed a guidance document designed to streamline the process without straying from essential and strict risk mitigation procedures.